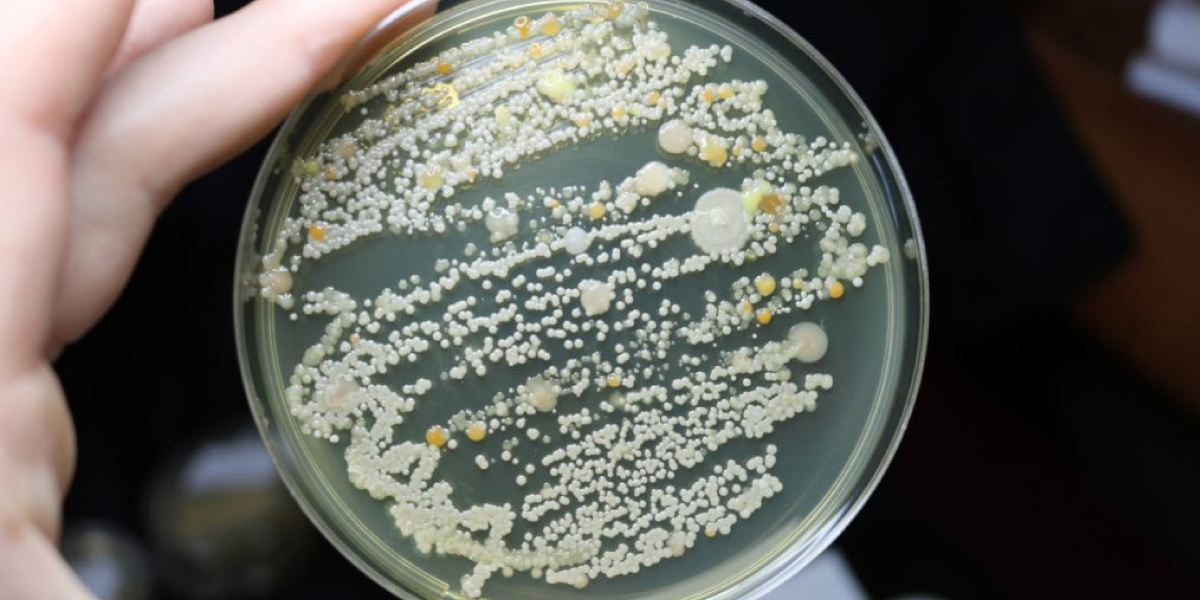
Use a Mold Test Kit

Water damage can lead to mold growth very quickly. If you’ve had a leak, flood, or plumbing issue, checking for mold is super important. Mold can damage your home and cause health problems.
So, how to check for mold after water damage? Check for mold by looking for black, green, or white spots, musty smells, and peeling paint in damp areas. Use a flashlight, moisture meter, or mold test kit to find hidden mold.
Let’s go step by step on how to check for mold and what to do if you find it.
Key Takeaways:
|
What is Mold, and Why Does It Grow After Water Damage?
Mold is a type of fungus that spreads through tiny spores in the air. It grows in damp, warm places, especially after water damage.
How Fast Does Mold Grow?
- Within 24-48 hours: Mold spores start multiplying in damp areas.
- After 3-7 days: You may start noticing visible mold spots.
- After a few weeks: Mold spreads deeper into walls, ceilings, and flooring.
Why is Mold Dangerous?
Mold is dangerous because it affects both health and homes. It can cause allergies, coughing, breathing problems, and skin irritation, especially for people with asthma.
In homes, mold slowly damages walls, ceilings, and wooden furniture, which makes them weak and unsafe. It also creates a strong, musty smell that lingers in the air. This actually makes rooms feel damp and unpleasant.
If mold is left untreated, it spreads quickly and leads to costly repairs and serious health issues.
How Does Water Damage Lead to Mold?

Mold needs moisture, warmth, and a surface to grow. Water damage creates the perfect environment for mold.
Common Places Where Mold Grows After Water Damage
| Location | Why Mold Grows There | Signs to Watch For |
| Walls & Ceilings | Water seeps inside and stays trapped | Peeling paint, dark spots, musty smell |
| Carpets & Rugs | Absorb water and stay damp | Wet spots, discoloration, musty odor |
| Basements | High humidity, poor ventilation | Moldy smell, black or green spots |
| Bathrooms | Steam and leaks cause moisture | Mold near sinks, bathtubs, and tiles |
| Air Vents & Ducts | Condensation collects inside | Musty air, dust buildup, breathing issues |
If your home had a flood, pipe leak, or roof leak, check these places first!
Signs That Mold Might Be Growing
You don’t always see mold immediately. Look for these warning signs:
Visible Mold Spots

- Black, green, white, or yellow patches on walls, ceilings, or furniture.
- Black mold from water leaks is especially harmful.
Musty Odor and Mold Smell

- A damp, earthy smell that lingers.
- If a room smells musty, mold is probably growing there.
Health Symptoms

- Coughing, sneezing, itchy eyes.
- Breathing problems, especially for people with asthma.
Changes in Your Home

- Peeling paint or warped walls = water behind the surface.
- Condensation on windows = too much moisture in the air.
Also, you can check out this insightful blog to learn more about the signs of water damage.
Steps on How to Check for Mold After Water Damage
Follow these steps below to inspect your home for mold.
Step 1: Check Areas with Water Damage

First, look at all the places that got wet, like walls, ceilings, carpets, and furniture. Don’t forget the corners, behind appliances, and under sinks. These spots can easily trap moisture and are where mold likes to grow.
Step 2: Use a Flashlight

Shine a flashlight into dark, hidden spots like basements, behind furniture, and inside cabinets. Mold loves to hide in these areas, so using light can help you spot it better.
Step 3: Check Behind Walls & Under Carpets

Gently pull back the wallpaper or lift up a small section of carpet. If you notice black or green patches, that’s definitely mold, and it means you need to deal with it fast.
Step 4: Use a Moisture Meter

A moisture meter helps find damp spots inside walls or floors. If the meter detects moisture, there’s a good chance mold is already growing there, so keep an eye out.
Step 5: Check for Condensation

Take a look at windows, pipes, and vents. If you see moisture building up, it’s a sign that mold can grow, especially inside air vents where it’s harder to notice.
Step 6: Use a Mold Test Kit (Optional)
If you’re unsure, you can buy a mold test kit to check for mold spores in the air. If the test comes back positive, it’s time to call a professional to help with mold removal.
Pro Tip: If mold is hiding inside walls or under floors, it’s tough to see. In these cases, it’s a smart idea to get professional mold remediation services to handle it.
At SOS Restoration, we provide expert mold removal and water damage restoration services. Our expert team uses advanced tools and techniques to remove mold and prevent it from coming back.
Our team is available 24/7 to help with any emergency. We offer affordable pricing and make sure you’re fully satisfied with the work.
Just give us a call, and we’ll take care of the rest!
What to Do If You Find Mold
If you see mold, take action fast!
Small Mold Patches (DIY Cleaning)
- Mix white vinegar or baking soda with water.
- Scrub the moldy area with a brush.
- Dry the area thoroughly with a fan or dehumidifier.
Large Mold Patches (Professional Help Needed)
- If mold covers more than 10 square feet, it’s time for professional mold remediation.
- Mold inside walls, ceilings, or air vents needs expert cleaning.
Severe Mold Infestations (Replace Materials)
- If drywall, insulation, or carpets are full of mold, they must be replaced.
- Mold will keep coming back if the moisture problem isn’t fixed.
Warning: Don’t try to remove black mold by yourself. It releases toxic spores that can be dangerous to breathe in.
How to Prevent Mold in the Future
Once you’ve removed mold, prevent it from coming back!
Fix Water Leaks
- Check pipes, sinks, and the roof for leaks.
- Repair any leaks immediately to avoid mold growth.
Improve Ventilation
- Open windows and use exhaust fans in the bathroom, kitchen, and basement.
- Run a dehumidifier if your home feels damp.
Control Humidity
- Keep indoor humidity below 50%.
- Use an air conditioner in humid weather.
Dry Wet Areas Fast
- After a flood or leak, dry everything within 24-48 hours.
- Use fans and a wet vacuum to remove standing water.
- For emergencies, contact a professional water damage restoration company.
Wrapping Up
So, coming to this point, we can hope that you now know how to check for mold after water damage. Checking for mold after water damage is super important to avoid health issues and property damage. Make sure to look in areas like walls, carpets, and basements, and use a moisture meter to find hidden damp spots.
If you see mold, clean small patches yourself, but call in experts for bigger areas.
Act quickly to prevent mold and keep your home safe and healthy!
Also, interested in learning how to get insurance to pay for water damage? Then you can visit this informative blog now!
FAQs
|

